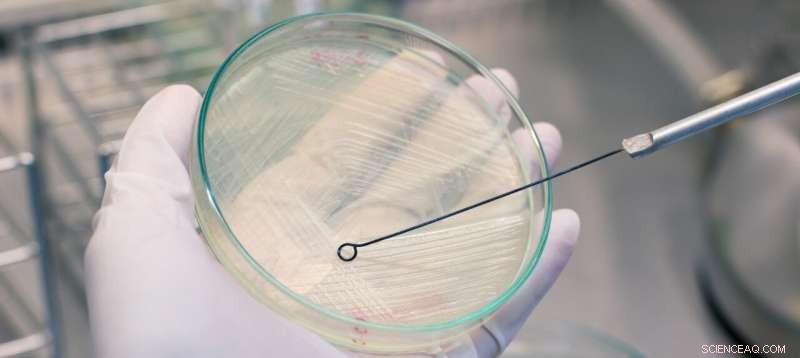
University of Oklahoma Study Reveals Climate Warming s Impact on Microbial Networks

Credit: University of Oklahoma
Climate change impacts are broad and far reaching. A new study by University of Oklahoma researchers from the Institute for Environmental Genomics explores the impacts of climate warming on microbial network complexity and stability, providing critical insights to ecosystem management and for projecting ecological consequences of future climate warming.
"Global climate change is one of the most profound anthropogenic disturbances to our planet," said Jizhong Zhou, IEG's director, a George Lynn Cross Research Professor in the College of Arts and Sciences and an adjunct professor in the Gallogly College of Engineering. "Climate warming can alter soil microbial community diversity, structure and activities, but it remains uncertain whether and how it impacts network complexity and its relationships to stability in microbial communities."
To understand whether and how climate warming affects the complexity and stability of ecological networks in soil microbial communities, the research team examined temporal dynamics of soil microbial communities in a long-term experiment carried out in a tallgrass prairie ecosystem in central Oklahoma.
"Our study provides explicit evidence that network complexity begets stability in microbial ecology," Zhou said. "Molecular ecological networks under warming became significantly more robust, with network stability strongly correlated with network complexity, supporting the central ecological belief that complexity begets stability."
"Furthermore, these results suggest that preserving microbial 'interactions' is critical for ecosystem management and for projecting ecological consequences of future climate warming," he added.
The study's findings have implications for projecting ecological consequences of future climate warming and for ecosystem management. Although climate warming has impacted decreased biodiversity and associated ecosystem functioning, this study suggests that the microbial community stability in the grassland ecosystem and the linked ecosystem functions could be less vulnerable in the warmer world.
The study, "Climate warming enhances microbial network complexity and stability," is published in Nature Climate Change.